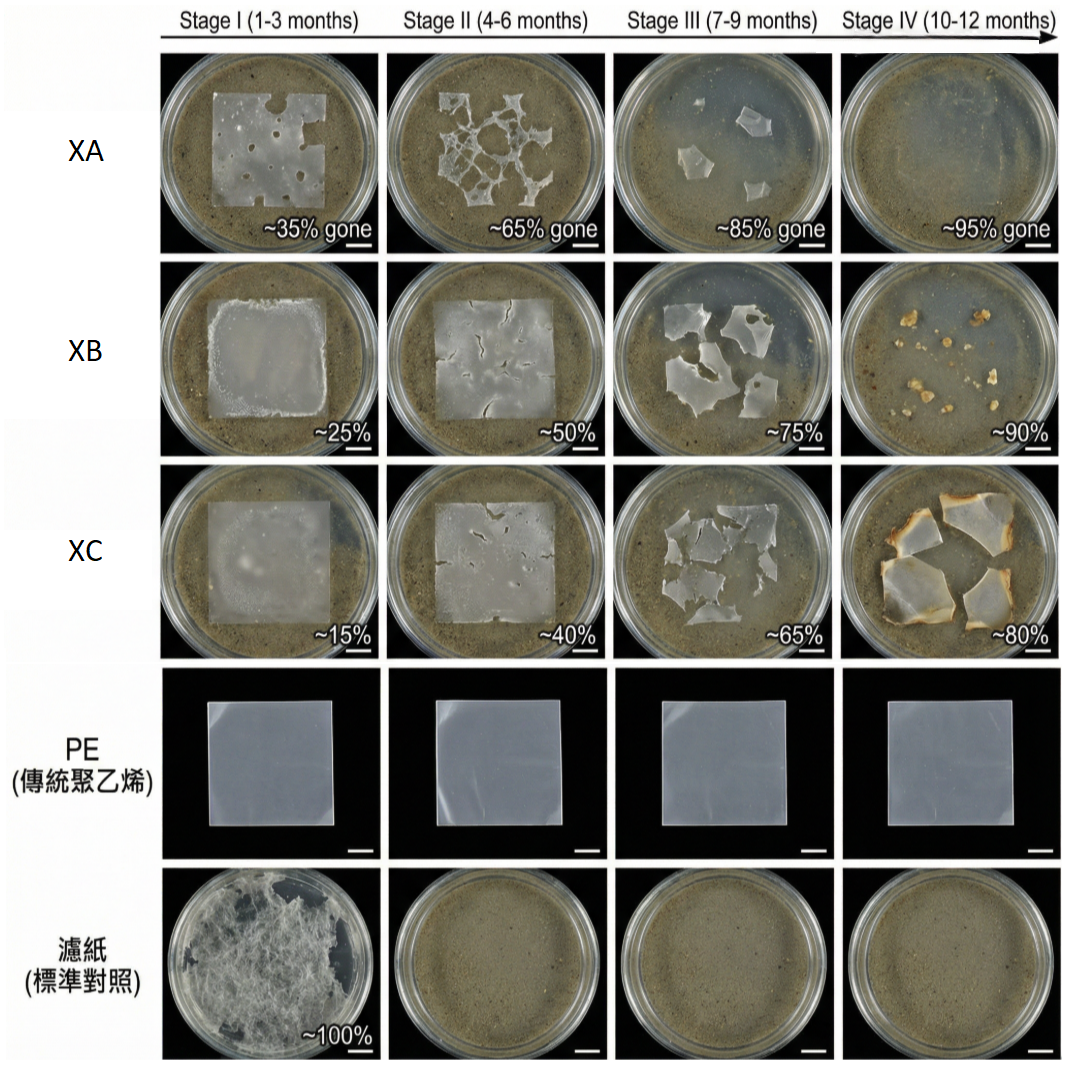

生質琥珀酸 Bio-succinic acid
CASE STUDY:我司以三種不同菌種配置而成的生質琥珀酸(XA、XB、XC),用來生產出具有生物降解性之生質塑膠(BioPBS),且在室溫、海水中可分解為碳水化合物。
透過數據進行模擬真實海洋環境分解實驗報告
實驗設置:
樣品: 2 cm x 2 cm 聚合物薄膜,厚度 100 μm。
材料:
XA 共聚物, XB 共聚物,XC 共聚物
對照組 (PE): 傳統聚乙烯薄膜
對照組 (濾紙): 標準定性濾紙
條件: 過濾自然海水,溫度控制於 25°C,持續輕微通氣以模擬海水流動與氧氣補充。
根據數值模擬測試:



這三種生質琥珀酸共聚物在海水生物降解評估中的預期表現。這些圖表整合了從化學表徵到環境命運的完整測試流程。






透過數據進行模擬真實海洋環境分解實驗報告
實驗設置:
樣品: 2 cm x 2 cm 聚合物薄膜,厚度 100 μm。
材料:
XA 共聚物, XB 共聚物,XC 共聚物
對照組 (PE): 傳統聚乙烯薄膜
對照組 (濾紙): 標準定性濾紙
條件: 過濾自然海水,溫度控制於 25°C,持續輕微通氣以模擬海水流動與氧氣補充。

根據數值模擬測試:



這三種生質琥珀酸共聚物在海水生物降解評估中的預期表現。這些圖表整合了從化學表徵到環境命運的完整測試流程。





